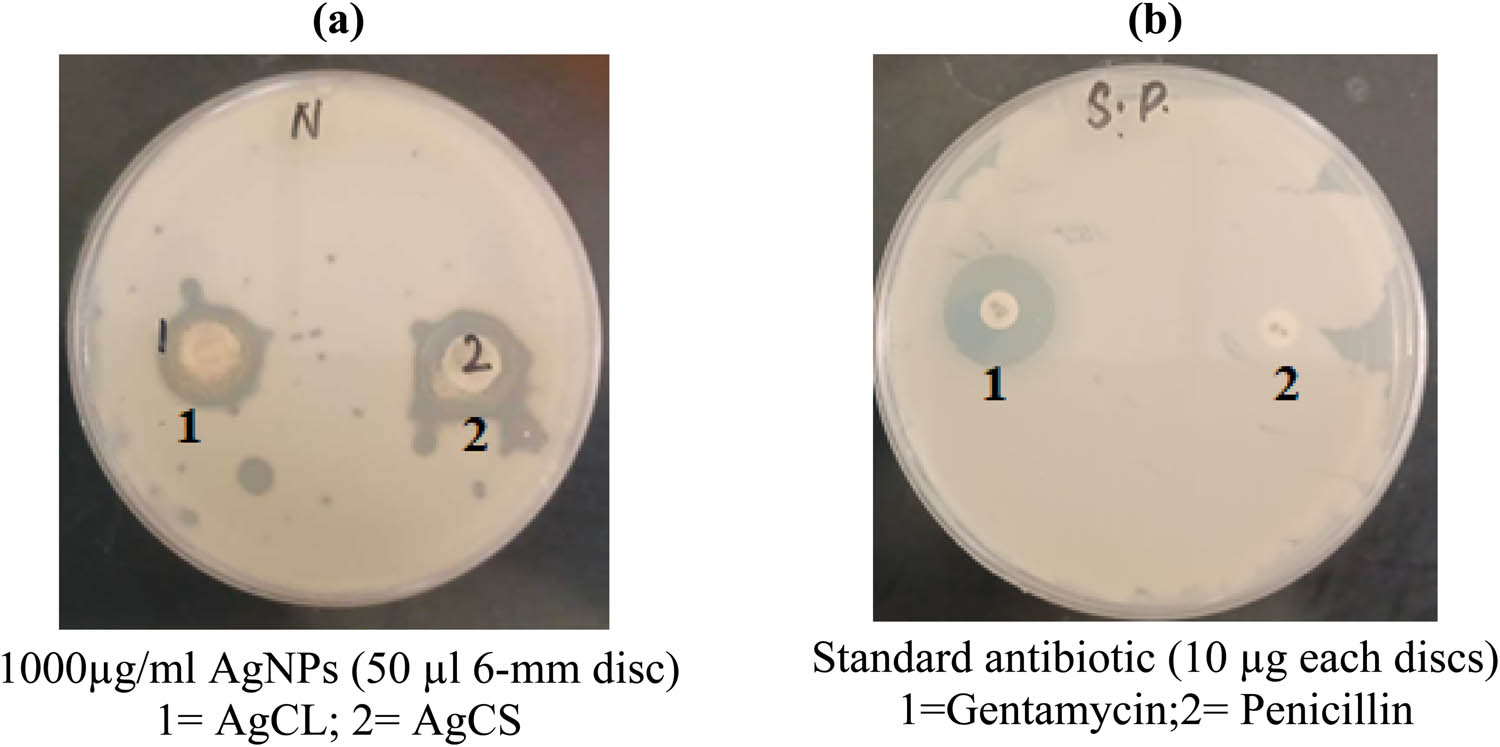

Abstract
Silver nanoparticles (AgNPs) are extensively studied as potent antibacterial agents targeting antibiotic-resistant pathogens. Cellular damage induced through various mechanisms that can affect multiple cell components like the outer membrane, enzymes, and proteins is closely linked to their chemical and morphological characteristics. We investigated the impact of AgNPs’ size on their antibacterial effectiveness using two differently sized nanoparticles: silver nanoparticle-Citrus limon (AgCL) with an average size of 21 nm and silver nanoparticle-Citrus sinensis (AgCS) with an average size of 13 nm, derived from C. limon and C. sinensis through environmentally friendly methods. The study evaluated their antibacterial effects by assessing morphology changes via scanning electron microscopy, metabolic alterations using Fourier transform infrared (FT-IR) spectroscopy, and oxidative stress responses through biochemical markers in Klebsiella pneumoniae cells exposed to AgNPs. The results showed that both AgCL and AgCS exhibited remarkable antibacterial activity, evidenced by inhibition zones of 14 ± 1.5 and 16 ± 1.0 mm, respectively. Morphological changes in K. pneumoniae cells treated with AgNPs were size dependent, with notable alterations noted. FT-IR spectroscopy revealed size and concentration-dependent biochemical changes, particularly in shifts in functional groups involved in the fluidity of cell wall lipid, and protein structure. Exposure to AgNPs led to increased oxidative stress markers like lipid peroxides and reduced levels of enzymatic and non-enzymatic antioxidants, more prominently observed with smaller AgCS nanoparticles (13 nm). AgNPs induce oxidative stress and morphological changes in K. pneumoniae strains, with smaller nanoparticles demonstrating greater efficacy. These findings underscore the importance of nanoparticle size in optimizing the antibacterial properties against pathogens.
1 Introduction
Metallic nanoparticles are at the top of the discussion due to the rising incidence of microbial infections and antibiotic resistance [1]. Numerous studies have highlighted metallic nanoparticles for antimicrobial effects against bacterial infections [2]. These particles induce oxidative stress, protein dysfunction, and damage to microbial cells’ membranes and DNA, leading to cell death [3,4]. Metallic nanoparticles occupy a unique size, typically less than 100 nm in at least one dimension with a high specific surface area and a greater number of surface atoms [5,6]. Compared to other metallic nanoparticles, silver has gained interest in recent decades [7,8,9]. These nanoparticles typically consist of 20–15,000 silver atoms and generally have diameters smaller than 100 nm [10,11]. Due to their high surface area-to-volume ratio, they exhibit significant antimicrobial activity, even at low concentrations [12]. Moreover, they are cost-effective and have demonstrated low cytotoxicity and minimal immunological response [13]. These characteristics make silver nanoparticles (AgNPs) highly promising for a range of biomedical applications. They are utilized in drug delivery systems, medical imaging, and molecular diagnostics. Additionally, AgNPs find application in therapeutic areas such as surgical mesh, artificial joint replacements, wound dressings, and formulations to enhance wound healing [14,15,16,17].
Several mechanisms behind the antibacterial effects of AgNPs have been proposed, but the exact mechanism is not fully understood. The continuous release of silver ions from AgNPs is the primary mechanism behind its antimicrobial activity [18,19]. These silver ions possess electrostatic attraction and a high affinity for sulfur-containing proteins, enabling them to bind to the bacterial cell wall and cytoplasmic membrane, increasing membrane permeability, and leading to disruption of the bacterial envelope [20,21]. Free silver ions can deactivate respiratory enzymes, triggering the production of reactive oxygen species (ROS) and disrupting adenosine triphosphate production inside the bacterial cells [22]. Sulfur and phosphorus are essential components of DNA, and the interaction between silver ions and these elements can interfere with DNA replication and cell division, potentially leading to microbial death [22]. Furthermore, silver ions can also inhibit protein synthesis by denaturing ribosomes in the bacterial cytoplasm [10]. The diameter of nanoparticles is a critical factor in influencing nanoparticle uptake by bacteria cells as smaller nanoparticles interact quickly and exhibit stronger antibacterial effects [23]. A higher surface area-to-mass ratio enhances their ability to penetrate bacterial membranes, thereby exerting potent antibiotic activity [24]. Smaller nanoparticles produce more radicals to combat infections by accelerating the dissolution rate of metallic ions from nanoparticles upon interaction with bacterial surfaces [23,24].
Multidrug-resistant strains are human pathogens responsible for infections like urinary tract infections, pneumonia, bloodstream infections, bacteremia, and sepsis [25,26]. Klebsiella pneumoniae, the second deadliest Gram-negative bacterium responsible for community and hospital-acquired bacteremia, has seen a significant increase in antibiotic resistance in recent years [27,28]. This trend poses a serious public health threat, as common infections like urinary tract infections become less responsive to antibiotic treatments. Consequently, managing infections caused by these pathogens has become increasingly difficult. AgNPs are in high demand for their applications in infectious diseases due to advanced drug delivery systems The unique properties of AgNP-based therapeutics and diagnostics offer promising prospects in overcoming challenges associated with acquired drug resistance in bacterial infections. Their specific size enables them to target resistant pathogenic strains effectively [29].
This research aimed to investigate the antibacterial mechanism of AgNPs mainly due to their particle size. Two differently sized Ag-NPs, produced using environmentally friendly methods were studied for their antibacterial effectiveness against the K. pneumoniae strain. This was assessed through the antibacterial activity followed by analyzing changes in cell morphology, composition, and biochemical modifications of K. pneumoniae cells in response to AgNPs of varying sizes.
2 Materials and methods
2.1 AgNPs
This study investigated two different sizes of AgNPs, with average diameters of 13 and 21 nm. The AgNPs were synthesized under optimized conditions per the methodology detailed in our recently published work [30]. Briefly, AgNPs were synthesized by gradually adding fresh juice of two different citrus fruit peels (Citrus sinensis and Citrus limon) into silver nitrate solution, maintaining a final silver nitrate concentration of 1 mM with constant stirring at room temperature. The color changes in solutions indicated the successful formation of AgNPs. Characterization of both types of nanoparticles included UV–Vis spectroscopy, zeta sizer analysis, zeta potential, transmission electron microscopy, scanning electron microscopy (SEM), and energy-dispersive X-ray spectroscopy [30]. The 13-nm nanoparticles, denoted as silver nanoparticle-C. sinensis (AgCS), were synthesized using C. sinensis fruit peels, whereas the 21 nm nanoparticles, labeled as Silver Nanoparticle-C. limon (AgCL), were synthesized using C. limon fruit peels.
2.2 Antibacterial
2.2.1 K. pneumoniae culture
The gram-negative strain of K. pneumoniae was obtained from King Khalid Hospital in Riyadh, Saudi Arabia. The strain was revived on nutrient agar plates before use.
2.2.2 Anti-K. pneumoniae activity
The antibacterial activity against K. pneumoniae of AgCS and AgCL (1,000 µg·mL−1) was evaluated using the disk diffusion method using 6 mm paper disks. Briefly, 20 µL of K. pneumoniae culture (106 CFU·mL−1) was evenly spread on sterile nutrient agar plates using a sterile cotton swab. After allowing the plates to dry for a few minutes, 50 µL of each test solution was applied to paper disks placed on the agar. Plates were incubated at 37°C for 18 h and the inhibitory zone (in mm) was measured [31].
2.2.3 Minimum inhibitory concentration (MIC) and minimum bactericidal concentrations (MBC)
The broth microdilution method was used to determine the MIC and MBC values of AgNPs. AgCS and AgCL were serially diluted in nutrient broth to achieve concentrations ranging from 3.90 to 2,000 µg·mL−1 AgNPs against K. pneumoniae cultures adjusted to approximately 106 CFU·mL−1. The plate was incubated at 37°C for 26 h to assess the turbidity. MIC was defined as the lowest AgNP concentration inhibiting K. pneumoniae growth, while MBC was defined as the concentration required to eliminate 99.9% of K. pneumoniae, indicated by no visible growth [32].
2.3 The growth kinetics, morphological, and biochemical changes in K. pneumoniae under AgNP stress
2.3.1 Growth curve
The growth curve of K. pneumoniae was studied under AgNP stress using two different-sized AgNPs (AgCS and AgCL) in sterilized nutrient broth. K. pneumoniae cells were incubated with 10 and 20 μg·mL−1 of nanoparticles separately at 37°C in a shaker incubator for 24 h. The growth curve was monitored and compared with normal K. pneumoniae growth taken as control. Optical density (OD) at 600 nm was noted to assess the growth curve.
2.3.2 Morphological changes by SEM
SEM was used to examine the morphological changes induced by AgNP exposure in K. pneumoniae cells treated for 24 h. AgCS- and AgCL-treated cells from a 10 μg·mL−1 batch were harvested for SEM to examine morphological alterations.
2.3.3 Biochemical changes by Fourier transform infrared (FT-IR) spectroscopy
FT-IR spectroscopy was utilized to identify the functional groups involved in biochemical changes, focusing on compositional and metabolic alterations in K. pneumoniae cells exposed to AgNPs, and comparing them to control cultures. FT-IR analysis was carried out on K. pneumoniae cells before and after AgCS and AgCL treatment each having a concentration of 10 and 20 μg·mL−1.
K. pneumoniae cells treated with 10 and 20 μg·mL−1 concentrations of AgCS and AgCL were initially monitored for growth curves. Due to insufficient cell counts in the 20 μg·mL−1 treatment batch, we proceeded with experiments investigating stress markers using the 10 μg·mL−1 concentrations of AgCS and AgCL.
2.4 Biochemical changes through stress markers in K. pneumoniae under AgNP treatment
K. pneumoniae cells incubated with 10 μg·mL−1 of AgCS and AgCL in nutrient broth were harvested after 24 h. The cells were centrifuged at 10,000 × g for 15 min and washed with ice-cold saline. Cells were sonicated and centrifuged at 10,000 × g for 15 min to get the clear supernatant for measurement of the following stress markers.
2.4.1 Lipid peroxides
Lipid peroxides were determined using the thiobarbituric acid reactive substances assay, which quantifies malondialdehyde and other lipid peroxidation products [33].
2.4.2 Reduced glutathione (GSH)
Reduced GSH levels were measured by using 5,5′-dithiobis(2-nitrobenzoic acid), to produce a yellow-colored product upon reacting with sulfhydryl groups [34].
2.4.3 Glutathione S-transferase (GST) activity
GST was evaluated by its catalytic reaction involving GSH, a substrate for GST, and 1-chloro-2,4-dinitrobenzene [35].
2.4.4 Ascorbic acid
Vitamin C levels were estimated by using the Folin–Ciocalteu reagent, resulting in a blue-colored complex [36].
2.4.5 Total crude protein
The total protein content was estimated using the Bradford method with bovine serum albumin as a standard [37].
2.5 Statistical analysis
The results are expressed as the mean ± standard deviation, with each experiment conducted three times.
3 Results
3.1 Antimicrobial activity
Disk diffusion tests were performed to assess the antibacterial effectiveness of AgCl and AgCS at a concentration of 1,000 μg·mL−1 against K. pneumoniae, as depicted in Figure 1. The antibacterial efficacy was evaluated through inhibition zone diameters, MIC, and MBC shown in Tables 1 and 2. The K. pneumoniae strains showed sensitivity to 50 μL disks of AgCL and AgCS, yielding inhibition zones of 14 ± 1.5 mm and 16 ± 1.0 mm, respectively (Table 1). Additionally, AgCL and AgCS exhibited bacteriostatic effects against K. pneumoniae showing MIC of 15.6 and 7.81 μg·mL−1, and MBC of 62.5 and 31.25 μg·mL−1, respectively (Table 2). Gentamicin and Penicillin (10 µg each on 6-mm disks, Condalab) served as the standard antibiotics. The K. pneumoniae strain exhibited sensitivity to the gentamicin disk, demonstrating an IZ of 18 mm, whereas it showed resistance to the penicillin disk with no observable inhibition.
Agar plates the antibacterial activity of (a) AgNPs and (b) standard antibiotic against K. pneumonia.
Inhibitory activity against K. pneumoniae by disk diffusion method
| Strain | Zone of inhibition (mm) | |||
|---|---|---|---|---|
| AgCL | AgCS | Std1 | Std 2 | |
| K. pneumonia | 14 ± 1.5 | 16 ± 1.0 | 18 | Resistant |
Standard antibiotic (Std) 1 – gentamycin (10 µg); 2 – pencilline (10 μg).
The MIC and MBC values of AgNPs against K. pneumonia
| Strain | MIC (µg·mL−1) | MBC (µg·mL−1) | ||
|---|---|---|---|---|
| K. pneumonia | AgCL | AgCS | AgCL | AgCS |
| 15.6 | 7.81 | 62.5 | 31.25 | |
3.2 K. pneumoniae growth curve, metabolic, and structural changes under AgNP stress
K. pneumoniae strains were evaluated for their sensitivity to AgCl and AgCS at 10 and 20 μg·mL−1. Figure 2 illustrates the bacterial growth rates under varying conditions with AgNPs. During the growth curve experiments, the suppression of bacterial growth was observed to correlate with nanoparticle size, demonstrating significantly stronger inhibition with AgCS (13 nm) than with AgCL (21 nm). Additionally, concentration-dependent inhibition was observed, as treatment with 20 μg·mL−1 showed more pronounced growth suppression than 10 μg·mL−1 compared to control.

Growth curves of K. pneumoniae incubated with AgCL and AgCS for 24 h (1 = 10 µg·mL−1; 2 = 20 µg·mL−1).
SEM analyses investigate size-dependent morphological changes induced by 10 μg·mL−1 of AgCL and AgCS on K. pneumoniae cells (Figure 3). K. pneumoniae cells grown in normal media were used as controls for comparison. Cells treated with AgCl and AgCS exhibited distinct characteristics. Specifically, Figure 3a (control or untreated) shows regular, smooth rod-shaped K. pneumoniae cells; Figure 3b (10 μg·mL−1 AgCL-treated) illustrates slight irregularities and cell aggregation; and Figure 3c (10 μg·mL−1 AgCS-treated) demonstrates cell rupture, aggregation, and destruction.

SEM micrograph showing the K. pneumoniae cells treated with 10 μg·mL−1 AgNPs: (a) control; (b) AgCL treated; and (c) AgCS treated.
Exposure to AgNPs caused specific changes in FT-IR spectra of K. pneumoniae cells, as depicted in Figure 4 and Table 3. Typically, FT-IR spectra of bacteria exhibit four distinct regions: Region I (3,000–2,800 cm−1) reflects cell membrane fatty acids, Region II (1,700–1,500 cm−1) includes the amide I (1,650 cm−1) and amide II (1,550 cm−1) bands of proteins and peptides, Region III (1,500–1,200 cm−1) corresponds to fatty acids, proteins, and phosphate-carrying molecules, and Region IV (1,200–900 cm−1) shows absorption bands characteristic of polysaccharides or carbohydrates in microbial cell walls. Our findings indicated shifts in peak positions across nearly all these regions, suggesting alterations in the biochemical composition of cells following exposure to AgNPs. Figure 4a depicts the FT-IR spectra of K. pneumoniae treated with AgCL and AgCS at 10 and 20 μg·mL−1 concentrations. Figure 4b compares the impact of different sizes of AgCL and AgCS on these spectra. The effect of varying concentrations of AgCL and AgCS on the FT-IR spectra of K. pneumoniae is shown in Figure 4. Remarkable shifts in FT-IR spectra were observed in a manner dependent on both size and concentration.

FT-IR spectra of K. pneumoniae treated with different AgNPs. (a) The FT-IR spectra of K. pneumoniae treated with AgNPs of various sizes. (b) The FT-IR spectra of K. pneumoniae treated with AgNPs at different concentrations N1 = AgCL; N2 = AgCS.
FT-IR spectra showing observed peaks and probable functional groups in AgNP-treated K. pneumoniae
| Wave number | Functional group | ||||
|---|---|---|---|---|---|
| Control | AgCL treated | AgCS treated | |||
| 10 μg·mL−1 | 20 μg·mL−1 | 10 μg·mL−1 | 20 μg·mL−1 | ||
| Region I (3,800–2,800 cm −1 ) | |||||
| 3,780.48 | 3,701.28 | 3,772.76 | 3,780.48 | O–H stretch, free hydroxyl alcohols, phenols | |
| 3,394.72 | 3,356.14 | 3,402.43 | N–H stretch primary, secondary amines, amides | ||
| 3,302.13 | 3,368.36 | 3,309.98 | 3,363.86 | O–H stretch (Alcohols), | |
| 3,209.56 | 3,209.55 | 3,248.13 | O–H stretch carboxylic acids | ||
| 3,070.68 | 3,163.26 | C–H stretch, aromatics | |||
| 3,032.10 | 3,024.38 | 3,024.28 | 3,024.38 | C–H stretch alkanes | |
| 2,939.10 | 2,916.37 | 2,916.37 | 2,916.37 | H–C═O: C–H stretch aldehydes | |
| Region II (2,800–1,500 cm −1 ) | |||||
| 2,376.30 | 2,360.87 | 2,368.59 | 2,368.59 | 2,368.59 | C(triple bond) N stretch nitriles |
| 2,152.56 | 2,217.13 | –C(triple bond)C– stretch alkynes | |||
| 1,944.25 | 1,944.25 | 1,944.25 | 1,944.25 | 1,944.25 | C═O stretch ketones, saturated aliphatic |
| 1,867.09 | 1874.81 | 1874.81 | C═O stretch aldehydes, saturated aliphatic | ||
| 1,651.07 | 1,797.66 | 1,797.66 | 1,797.66 | 1,597.06 | –C═C– stretch alkenes; C═O aldehyde |
| 1,507.06 | 1,597.06 | 1,597.06 | 1,527.62 | N–O asymmetric stretch nitro compounds | |
| Region III (1,500–1,200 cm −1 ) | |||||
| 1,469.76 | 1,496.76 | 1,496.76 | C–H bend alkanes | ||
| 1,450.47 | 1,450.47 | 1,450.47 | 1,450.47 | N–H bend (Nitro compounds), | |
| 1,404.18 | 1,404.18 | 1,404.18 | 1,404.18 | 1,404.18 | N–O asymmetric stretch nitro compounds |
| 1,242.46 | C–N stretch aliphatic amines | ||||
| Region IV (1,200–900 cm −1 ) | |||||
| 1,149.57 | 1,149.57 | C–O stretch alcohols, carboxylic acids, esters | |||
| 1,072.42 | 1,072.42 | 1,080.14 | ═C–H bend (Alkenes) | ||
| 1,026.13 | 1,026.13 | 1,026.13 | 1,033.85 | C═C–H bend (Alkenes) (Pectin) | |
| 910.40 | 910.40 | 910.40 | 918.12 | ═C–H bend (Benzene), C–C stretch (fluorides) | |
| 840.96 | C–N stretch (amines) | ||||
| 748.38 | 756.10 | 756.10 | 756.10 | 756.10 | C–N stretch (amines) |
| 694.37 | 694.37 | 694.37 | 694.37 | ═C–H bend (chlorides) | |
| 624.94 | 617.22 | ═C–H bend (bromides) | |||
| 532.35 | 540.07 | 540.07 | 532.35 | 532.35 | C–C stretch (iodide) |
3.3 Biochemical changes through stress markers in K. pneumoniae under AgNP treatment
K. pneumoniae cells treated with 10 μg·mL−1 of AgCL and AgCS were evaluated for stress markers, as illustrated in Figure 5. Both types of AgNPs increased lipid peroxide levels, while a decrease in GSH, ascorbic acid, GST activity, and total protein levels was observed upon exposure. AgCS exhibited stronger effects on these stress markers than AgCL, as indicated in Figure 5.

The oxidative stress markers in K. pneumoniae under AgNP (10 μg·mL−1) treatment. (a) Lipid peroxidation (MDA), (b) reduced GSH, (c) glutathione S-transferase activity, (d) ascorbic acid, and (e) total crude protein.
4 Discussion
Numerous studies have documented the antibacterial properties of AgNPs, but their intricate mechanism is not fully clear. This study investigates the impact of two different-sized AgNPs on the growth, biochemical profiles, and morphological changes related to oxidative stress in penicillin-resistant strains of K. pneumoniae. K. pneumoniae is a prevalent antibiotic-resistant bacterium that poses a substantial global public health threat. Given the challenges posed by antibiotic resistance, identifying novel therapeutic agents is imperative for effectively combating K. pneumoniae infections.
In this study, AgNPs of two different sizes were evaluated against K. pneumoniae: AgCL with an average diameter of 21 nm and AgCS with an average diameter of 13 nm. The results demonstrated that AgCS (13 nm) exhibited superior antibacterial activity compared to AgCL, suggesting an inverse relationship between particle size and bactericidal efficacy (Tables 1 and 2). This highlights the enhanced effectiveness of smaller-sized AgNPs in exerting antibacterial effects [38]. Smaller nanoparticles possess larger surface areas, facilitating increased release of Ag ions and improved interaction with bacterial cell membranes [39]. The antibacterial activity in this study was assessed using the disk diffusion method, which is particularly suitable for evaluating the antibacterial efficacy of Ag ions due to their ability to diffuse freely through agar matrices [40] (Figure 1). Cellular uptake and toxic level of AgNPs against bacteria mainly depend on their size [41]. The growth curves of K. pneumoniae treated with AgCS and AgCL reveal the lowest maximum OD and the longest lag time compared to untreated K. pneumoniae (Figure 2). Additionally, when bacteria are exposed to higher concentrations of NPs, the initial OD decreases, and this decline continues consistently over time, contrasting with lower nanoparticle concentrations. These findings underscore the dual impact of AgNP size and concentration on bacterial toxicity.
Our primary focus was the biochemical and morphological changes induced in K. pneumoniae cells with AgNP treatment. SEM was utilized to observe the surface morphology of K. pneumoniae, a widely used technique for visualizing bacterial structures [42]. Untreated cells exhibited a clear cell wall structure without any discernible alterations, whereas cells treated with AgCS and AgCL displayed distinct changes (Figure 3). AgCS-treated K. pneumoniae cells showed more irregular shapes, along with cell shrinkage, aggregation, and lysis compared to AgCL treated. These findings indicate that AgNPs induce size-dependent morphological changes by damaging bacterial membranes and causing leakage of cytoplasmic material.
Our SEM observations were further supported by FT-IR spectroscopic analysis of treated cells, (Table 3 and Figure 4) which revealed significant shifts across all four spectral regions (Regions I–IV). These shifts confirmed the morphological changes observed in SEM. More band shifts were observed with AgCS compared to AgCL mainly in the 3,400–2,900 cm−1 range confirming the membrane alterations to damage the outer cell membrane to enable the entry of AgNPs into the cells (Figure 4a). FT-IR spectroscopy allows for rapid characterization of biochemical structural alterations in bacteria exposed to nanoparticles [43]. The technique identifies distinct regions for fatty acids, proteins peptides, carbohydrates, and fingerprints [44]. FT-IR is notably faster than conventional methods, applicable across various bacteria, and specific in differentiating chemical effects on intracellular levels [45]. Therefore, it facilitates clear discrimination between chemically exposed bacteria and controls, aiding in the rapid assessment of nanoparticle toxicity levels. Our results suggest several potential antimicrobial mechanisms. AgCS and AgCL may alter the fluidity of cell wall lipids by interacting with –CH groups of the membrane, as evidenced by shifts in the 3,400–2,900 cm−1 range. Additionally, binding with amino acids in proteins and enzymes, resulting in changes to protein structures, was detected by shifts in the 1,500–2,000 cm−1 range. Moreover, catalyzed oxidation and generation of ROS by AgCS and AgCL could lead to alterations in polysaccharide structures, indicated by shifts in the 900–1,200 cm−1 range (Figure 4b, c).
Exposure to AgCS and AgCL resulted in oxidative damage, indicated by elevated oxidative markers such as lipid peroxides in K. pneumoniae cells. Concurrently, there was a depletion observed in both enzymatic and non-enzymatic antioxidants, notably GSH and GST (Figure 5). GSH is predominantly consumed through GST-catalyzed reactions, which serve as a crucial detoxification mechanism in bacterial cells [46,47]. These responses underscore the defense strategies employed by K. pneumoniae to mitigate oxidative stress induced by exposure to AgCS and AgCL. The toxicity of Ag NPs to bacterial cells is primarily attributed to Ag ions. Ag ions disrupt the bacterial respiratory chain and bind to sulfhydryl groups within the cellular membrane and essential enzymes, thereby causing damage to the bacteria [48]. The size-dependent antibacterial activity in our results is due to the faster dissolution of smaller nanoparticles, leading to increased release of Ag+ ions. Another critical factor contributing to AgCS and AgCL’s antibacterial properties in our results is the generation of ROS, which induces oxidative stress and apoptosis in cells [49]. ROS production triggered by AgNPs operates through two main mechanisms. First, reactive groups like radicals or oxidants, often present on the nanoparticle surface, directly contribute to ROS formation. Second, AgNPs can deactivate ROS protection pathways, such as damaging GSH, a typical cellular antioxidant, thereby reducing scavenging activity against ROS [50].
5 Conclusions
AgNPs have been extensively studied as antibacterial agents against multidrug-resistant pathogens. We examined the impact of AgNPs of varying sizes on cellular damage in penicillin-resistant K. pneumoniae cells through various mechanisms. The efficacy of AgNPs against K. pneumoniae showed a strong correlation with their size and concentration. We examined morphological changes and modifications in functional groups resulting from nanoparticle treatments to evaluate their antibacterial efficacy. In cells exposed to AgNPs, we noted biochemical alterations such as reductions in GSH, GST, ascorbic acid, and total protein along with increases in lipid peroxidation. Due to the low cell count after treatment with 20 µg·mL−1 AgNPs, we limited the investigation of stress markers to a 10 µg·mL−1 concentration of AgNPs. Developing biocompatible silver-based agents to combat multidrug resistance could significantly aid in controlling harmful infections.
Acknowledgments
The authors appreciate the Researchers Supporting Project number (RSP 2024R237), King Saud University, Riyadh, Saudi Arabia.
-
Funding information: This research project was supported by Researchers Supporting Project number (RSP 2024R237), King Saud University, Riyadh, Saudi Arabia.
-
Author contributions: Ramesa Shafi Bhat: writing – original draft, writing – review and editing, methodology, formal analysis; visualization. Mona Alonazi: resources. Abeer M. Aldbass: formal analysis. Sooad Al-Daihan: writing – review and editing.
-
Conflict of interest: Authors state no conflict of interest.
-
Data availability statement: All data generated or analyzed during this study are included in this published article.
References
[1] Skłodowski K, Chmielewska-Deptuła SJ, Piktel E, Wolak P, Wollny T, Bucki R. Metallic nanosystems in the development of antimicrobial strategies with high antimicrobial activity and high biocompatibility. Int J Mol Sci. 2023;24(3):2104. 10.3390/ijms24032104. Published 2023 Jan 20.Search in Google Scholar PubMed PubMed Central
[2] Yılmaz GE, Göktürk I, Ovezova M, Yılmaz F, Kılıç S, Denizli A. Antimicrobial nanomaterials: a review. Hygiene. 2023;3:269–90. 10.3390/hygiene3030020.Search in Google Scholar
[3] Jiang H, Li L, Li Z, Chu X. Metal-based nanoparticles in antibacterial application in biomedical field: Current development and potential mechanisms. Biomed Microdevices. 2024;26(1):12. 10.1007/s10544-023-00686-8. Published 2024 Jan 23.Search in Google Scholar PubMed PubMed Central
[4] Rehman Y, Qutaish H, Kim JH, Huang XF, Alvi S, Konstantinov K. Microenvironmental behaviour of nanotheranostic systems for controlled oxidative stress and cancer treatment. Nanomaterials (Basel). 2022;12(14):2462. 10.3390/nano12142462. Published 2022 Jul 18.Search in Google Scholar PubMed PubMed Central
[5] Issa B, Obaidat IM, Albiss BA, Haik Y. Magnetic nanoparticles: surface effects and properties related to biomedicine applications. Int J Mol Sci. 2013;14(11):21266–305. 10.3390/ijms141121266. Published 2013 Oct 25.Search in Google Scholar PubMed PubMed Central
[6] Saleh HM, Hassan AI. Synthesis and characterization of nanomaterials for application in cost-effective electrochemical devices. Sustainability. 2023;15:10891. 10.3390/su151410891.Search in Google Scholar
[7] Xu L, Wang YY, Huang J, Chen CY, Wang ZX, Xie H. Silver nanoparticles: Synthesis, medical applications and biosafety. Theranostics. 2020;10(20):8996–9031. 10.7150/thno.45413. Published 2020 Jul 11.Search in Google Scholar PubMed PubMed Central
[8] Bouafia A, Laouini SE, Ahmed ASA, Soldatov AV, Algarni H, Feng Chong K, et al. The recent progress on silver nanoparticles: synthesis and electronic applications. Nanomaterials (Basel). 2021;11(9):2318. 10.3390/nano11092318. Published 2021 Sep 6.Search in Google Scholar PubMed PubMed Central
[9] Akhatova F, Konnova S, Kryuchkova M, Batasheva S, Mazurova K, Vikulina A, et al. Comparative characterization of iron and silver nanoparticles: extract-stabilized and classical synthesis methods. Int J Mol Sci. 2023;24:9274. 10.3390/ijms24119274.Search in Google Scholar PubMed PubMed Central
[10] Yin IX, Zhang J, Zhao IS, Mei ML, Li Q, Chu CH. The antibacterial mechanism of silver nanoparticles and its application in dentistry. Int J Nanomed. 2020;15:2555–62. 10.2147/IJN.S246764. Published 2020 Apr 17.Search in Google Scholar PubMed PubMed Central
[11] Kowalczyk P, Szymczak M, Maciejewska M, Laskowski Ł, Laskowska M, Ostaszewski R, et al. all that glitters is not silver—a new look at microbiological and medical applications of silver nanoparticles. Int J Mol Sci. 2021;22:854. 10.3390/ijms22020854.Search in Google Scholar PubMed PubMed Central
[12] Sharma PC, Sharma D, Sharma A, Saini N, Goyal R, Ola M, et al. Hydrazone comprising compounds as promising anti-infective agents: chemistry and structure-property relationship. Mater Today Chem. 2020;18:100349.10.1016/j.mtchem.2020.100349Search in Google Scholar
[13] Bezbaruah R, Chavda VP, Nongrang L, Alom S, Deka K, Kalita T, et al. Nanoparticle-based delivery systems for vaccines. Vaccines (Basel). 2022;10(11):1946. 10.3390/vaccines10111946. Published 2022 Nov 17.Search in Google Scholar PubMed PubMed Central
[14] Amiri N, Ghaffari S, Hassanpour I, Chae T, Jalili R, Kilani RT, et al. Antibacterial thermosensitive silver–hydrogel nanocomposite improves wound healing. Gels. 2023;9:542. 10.3390/gels907054.Search in Google Scholar
[15] Frykberg RG, Banks J. Challenges in the treatment of chronic wounds. Adv Wound Care. 2015;4:560–82.10.1089/wound.2015.0635Search in Google Scholar PubMed PubMed Central
[16] Raziyeva K, Kim Y, Zharkinbekov Z, Kassymbek K, Jimi S, Saparov A. Immunology of acute and chronic wound healing. Biomolecules. 2021;11:700.10.3390/biom11050700Search in Google Scholar PubMed PubMed Central
[17] Clinton A, Carter T. Chronic wound biofilms: pathogenesis and potential therapies. Lab Med. 2015;46:277–84.10.1309/LMBNSWKUI4JPN7SOSearch in Google Scholar PubMed
[18] Ahmad A, Haneef M, Ahmad N, Kamal A, Jaswani S, Khan F. Biological synthesis of silver nanoparticles and their medical applications (Review). World Acad Sci J. 2024;6:22. 10.3892/wasj.2024.237.Search in Google Scholar
[19] Mikhailova EO. Silver nanoparticles: mechanism of action and probable bio-application. J Funct Biomater. 2020;11(4):84. 10.3390/jfb11040084. Published 2020 Nov 26.Search in Google Scholar PubMed PubMed Central
[20] Bondarenko OM, Sihtmäe M, Kuzmičiova J, Ragelienė L, Kahru A, Daugelavičius R. Plasma membrane is the target of rapid antibacterial action of silver nanoparticles in Escherichia coli and Pseudomonas aeruginosa. Int J Nanomed. 2018;13:6779–90. 10.2147/IJN.S177163. Published 2018 Oct 26.Search in Google Scholar PubMed PubMed Central
[21] Godoy-Gallardo M, Eckhard U, Delgado LM, de Roo Puente YJD, Hoyos-Nogués M, Gil FJ, et al. Antibacterial approaches in tissue engineering using metal ions and nanoparticles: From mechanisms to applications. Bioact Mater. 2021;6(12):4470–90. 10.1016/j.bioactmat.2021.04.033. Published 2021 May 8.Search in Google Scholar PubMed PubMed Central
[22] More PR, Pandit S, Filippis A, Franci G, Mijakovic I, Galdiero M. Silver nanoparticles: bactericidal and mechanistic approach against drug resistant pathogens. Microorganisms. 2023;11(2):369. 10.3390/microorganisms11020369. Published 2023 Feb 1.Search in Google Scholar PubMed PubMed Central
[23] Abbasi R, Shineh G, Mobaraki M, Doughty S, Tayebi L. Structural parameters of nanoparticles affecting their toxicity for biomedical applications: a review. J Nanopart Res. 2023;25:43. 10.1007/s11051-023-05690-w.Search in Google Scholar PubMed PubMed Central
[24] Huang Y, Guo X, Wu Y, Chen X, Feng L, Xie N, et al. Nanotechnology’s frontier in combatting infectious and inflammatory diseases: prevention and treatment. Signal Transduction Targeted Ther. 2024;9:34. 10.1038/s41392-024-01745-z.Search in Google Scholar PubMed PubMed Central
[25] Bharadwaj A, Rastogi A, Pandey S, Gupta S, Sohal JS. Multidrug-resistant bacteria: their mechanism of action and prophylaxis. Biomed Res Int. 2022;2022:5419874. 10.1155/2022/5419874. Published 2022 Sep 5.Search in Google Scholar PubMed PubMed Central
[26] Bouhrour N, Nibbering PH, Bendali F. Medical device-associated biofilm infections and multidrug-resistant pathogens. Pathogens. 2024;13:393. 10.3390/pathogens13050393.Search in Google Scholar PubMed PubMed Central
[27] Navon-Venezia S, Kondratyeva K. Carattoli AKlebsiella pneumoniae: a major worldwide source and shuttle for antibiotic resistance. FEMS Microbiol Rev. 2017;41:252–75.10.1093/femsre/fux013Search in Google Scholar PubMed
[28] Nahid F, Zahra R, Sandegren L. A blaOXA-181-harbouring multi-resistant ST147 Klebsiella pneumoniae isolate from Pakistan that represent an intermediate stage towards pan-drug resistance. PLoS One. 2017;12(12):e0189438.10.1371/journal.pone.0189438Search in Google Scholar PubMed PubMed Central
[29] Bruna T, Maldonado-Bravo F, Jara P, Caro N. Silver nanoparticles and their antibacterial applications. Int J Mol Sci. 2021;22(13):7202. 10.3390/ijms22137202. Published 2021 Jul 4.Search in Google Scholar PubMed PubMed Central
[30] Bhat RS, Al-Dbass AM, Khayyat AIA, Al-Daihan S. Utilizing biomolecule-rich citrus fruit waste as a medium for the eco-friendly preparation of silver nanoparticles with antimicrobial properties. Inorganics. 2024;12:180. 10.3390/inorganics12070180.Search in Google Scholar
[31] Bhat RS, Al-Daihan S. Phytochemical constituents and antibacterial activity of some green leafy vegetables. Asian Pac J Trop Biomed. 2014;4(3):189–93. 10.1016/S2221-1691(14)60230-6.Search in Google Scholar PubMed PubMed Central
[32] Bhat RS, Al-Daihan S, Aldabass AM. Anti-biofilm and antimicrobial activity of sodium fluoride against various pathogenic microbes. Fluoride. 2024;57(1):1.Search in Google Scholar
[33] Aguilar Diaz De Leon J, Borges CR. Evaluation of oxidative stress in biological samples using the thiobarbituric acid reactive substances assay. J Visual Exp. 2020;159:10.3791/61122. 10.3791/6112210.3791/61122. Published 2020 May 12.Search in Google Scholar
[34] Iwasaki Y, Saito Y, Nakano Y, Mochizuki K, Sakata O, Ito R, et al. Chromatographic and mass spectrometric analysis of glutathione in biological samples. J Chromatogr B. 2009;877:3309–17.10.1016/j.jchromb.2009.07.001Search in Google Scholar PubMed
[35] Seyyedi MA, Farahnak A, Jalali M, Rokni MB. Study on glutathione S-transferase (GST) inhibition assay by triclabendazole. protoscoleces (hydatid cyst; echinococcus granulosus) and sheep liver tissue. Iran J Public Health. 2005;34(1):38–46.Search in Google Scholar
[36] Kupina S, Fields C, Roman MC, Brunelle SL. Determination of total phenolic content using the folin-C assay: single-laboratory validation, first action 2017.13. J AOAC Int. 2018;101(5):1466–72. 10.5740/jaoacint.18-0031.Search in Google Scholar PubMed
[37] Bradford MM. A rapid and sensitive method for the quantitation of microgram quantities of protein utilizing the principle of protein-dye binding. Anal Biochem. 1976;72:248–54.10.1006/abio.1976.9999Search in Google Scholar PubMed
[38] Moraes G, Zambom C, Siqueira WL. Nanoparticles in dentistry: a comprehensive review. Pharmaceuticals. 2021;14:752. 10.3390/ph14080752.Search in Google Scholar PubMed PubMed Central
[39] Gautam S, Das DK, Kaur J, Kumar A, Ubaidullah M, Hasan M, et al. Transition metal-based nanoparticles as potential antimicrobial agents: recent advancements, mechanistic, challenges, and future prospects. Discovery Nano. 2023;18:84. 10.1186/s11671-023-03861-1.Search in Google Scholar PubMed PubMed Central
[40] Chung E, Ren G, Johnston I, Matharu RK, Ciric L, Walecka A, et al. Applied methods to assess the antimicrobial activity of metallic-based nanoparticles. Bioengineering (Basel). 2023;10(11):1259. 10.3390/bioengineering10111259. Published 2023 Oct 28.Search in Google Scholar PubMed PubMed Central
[41] Zapór L. Effects of silver nanoparticles of different sizes on cytotoxicity and oxygen metabolism disorders in both reproductive and respiratory system cells. Arch Environ Prot. 2016;42(4):32–47. 10.1515/aep-2016-0038, 2-s2.0-85007086252.Search in Google Scholar
[42] Czerwińska-Główka D, Krukiewicz K. Guidelines for a morphometric analysis of prokaryotic and eukaryotic cells by scanning electron microscopy. Cells. 2021;10(12):3304. 10.3390/cells10123304. Published 2021 Nov 25.Search in Google Scholar PubMed PubMed Central
[43] Faghihzadeh F, Anaya NM, Schifman LA, Oyanedel-Craver V. Fourier transform infrared spectroscopy to assess molecular-level changes in microorganisms exposed to nanoparticles. Nanotechnol Environ Eng. 2016;1:1. 10.1007/s41204-016-0001-8.Search in Google Scholar
[44] Bhat RS, Alghamdi JM, Aldbass AM, Aljebrin NA, Alangery AB, Soliman DA, et al. Biochemical and FT-IR pro-filing of Tritium aestivum L. seedling in response to sodium fluoride treatment. Fluoride. 2022;55:81–9.Search in Google Scholar
[45] Bhat RS, Al-Dbass AM, Alghamdia JM, Alonazia MA, Al-Daihan S. Trigonella foenum-graecum L. Seed germination under sodium halide salts exposure. Res Rep Fluoride. 2023;56:169–79.Search in Google Scholar
[46] Masip L, Veeravalli K, Georgiou G. The many faces of glutathione in bacteria. Antioxid Redox Signal. 2006 May–Jun;8(5–6):753–62. 10.1089/ars.2006.8.753. PMID: 16771667.Search in Google Scholar PubMed
[47] Bhat RS, Soliman DA, Al-Daihan S. Sodium fluoride induces oxidative stress in oral bacteria by altering glutathione (GSH) and glutathione S transferase (GST) activity. Fluoride. 2021;54(1):90–6.Search in Google Scholar
[48] Jahan I, Matpan Bekler F, Tunç A, Güven K. The effects of silver nanoparticles (AgNPs) on thermophilic bacteria: antibacterial, morphological, physiological and biochemical investigations. Microorganisms. 2024;12:402. 10.3390/microorganisms12020402.Search in Google Scholar PubMed PubMed Central
[49] Juan CA, Pérez de la Lastra JM, Plou FJ, Pérez-Lebeña E. The Chemistry of reactive oxygen species (ROS) revisited: outlining their role in biological macromolecules (DNA, lipids and proteins) and induced pathologies. Int J Mol Sci. 2021;22:4642. 10.3390/ijms22094642.Search in Google Scholar PubMed PubMed Central
[50] Bhat RS, Almusallam J, Al Daihan S, Al-Dbass A. Biosynthesis of silver nanoparticles using Azadirachta indica leaves: Characterisation and impact on Staphylococcus aureus growth and Glutathione-S-transferase activity. IET Nanobiotechnol. 2019;13:498–502.10.1049/iet-nbt.2018.5133Search in Google Scholar
© 2024 the author(s), published by De Gruyter
This work is licensed under the Creative Commons Attribution 4.0 International License.
Articles in the same Issue
- Research Articles
- Green polymer electrolyte and activated charcoal-based supercapacitor for energy harvesting application: Electrochemical characteristics
- Research on the adsorption of Co2+ ions using halloysite clay and the ability to recover them by electrodeposition method
- Simultaneous estimation of ibuprofen, caffeine, and paracetamol in commercial products using a green reverse-phase HPTLC method
- Isolation, screening and optimization of alkaliphilic cellulolytic fungi for production of cellulase
- Functionalized gold nanoparticles coated with bacterial alginate and their antibacterial and anticancer activities
- Comparative analysis of bio-based amino acid surfactants obtained via Diels–Alder reaction of cyclic anhydrides
- Biosynthesis of silver nanoparticles on yellow phosphorus slag and its application in organic coatings
- Exploring antioxidant potential and phenolic compound extraction from Vitis vinifera L. using ultrasound-assisted extraction
- Manganese and copper-coated nickel oxide nanoparticles synthesized from Carica papaya leaf extract induce antimicrobial activity and breast cancer cell death by triggering mitochondrial caspases and p53
- Insight into heating method and Mozafari method as green processing techniques for the synthesis of micro- and nano-drug carriers
- Silicotungstic acid supported on Bi-based MOF-derived metal oxide for photodegradation of organic dyes
- Synthesis and characterization of capsaicin nanoparticles: An attempt to enhance its bioavailability and pharmacological actions
- Synthesis of Lawsonia inermis-encased silver–copper bimetallic nanoparticles with antioxidant, antibacterial, and cytotoxic activity
- Facile, polyherbal drug-mediated green synthesis of CuO nanoparticles and their potent biological applications
- Zinc oxide-manganese oxide/carboxymethyl cellulose-folic acid-sesamol hybrid nanomaterials: A molecularly targeted strategy for advanced triple-negative breast cancer therapy
- Exploring the antimicrobial potential of biogenically synthesized graphene oxide nanoparticles against targeted bacterial and fungal pathogens
- Biofabrication of silver nanoparticles using Uncaria tomentosa L.: Insight into characterization, antibacterial activities combined with antibiotics, and effect on Triticum aestivum germination
- Membrane distillation of synthetic urine for use in space structural habitat systems
- Investigation on mechanical properties of the green synthesis bamboo fiber/eggshell/coconut shell powder-based hybrid biocomposites under NaOH conditions
- Green synthesis of magnesium oxide nanoparticles using endophytic fungal strain to improve the growth, metabolic activities, yield traits, and phenolic compounds content of Nigella sativa L.
- Estimation of greenhouse gas emissions from rice and annual upland crops in Red River Delta of Vietnam using the denitrification–decomposition model
- Synthesis of humic acid with the obtaining of potassium humate based on coal waste from the Lenger deposit, Kazakhstan
- Ascorbic acid-mediated selenium nanoparticles as potential antihyperuricemic, antioxidant, anticoagulant, and thrombolytic agents
- Green synthesis of silver nanoparticles using Illicium verum extract: Optimization and characterization for biomedical applications
- Antibacterial and dynamical behaviour of silicon nanoparticles influenced sustainable waste flax fibre-reinforced epoxy composite for biomedical application
- Optimising coagulation/flocculation using response surface methodology and application of floc in biofertilisation
- Green synthesis and multifaceted characterization of iron oxide nanoparticles derived from Senna bicapsularis for enhanced in vitro and in vivo biological investigation
- Potent antibacterial nanocomposites from okra mucilage/chitosan/silver nanoparticles for multidrug-resistant Salmonella Typhimurium eradication
- Trachyspermum copticum aqueous seed extract-derived silver nanoparticles: Exploration of their structural characterization and comparative antibacterial performance against gram-positive and gram-negative bacteria
- Microwave-assisted ultrafine silver nanoparticle synthesis using Mitragyna speciosa for antimalarial applications
- Green synthesis and characterisation of spherical structure Ag/Fe2O3/TiO2 nanocomposite using acacia in the presence of neem and tulsi oils
- Green quantitative methods for linagliptin and empagliflozin in dosage forms
- Enhancement efficacy of omeprazole by conjugation with silver nanoparticles as a urease inhibitor
- Residual, sequential extraction, and ecological risk assessment of some metals in ash from municipal solid waste incineration, Vietnam
- Green synthesis of ZnO nanoparticles using the mangosteen (Garcinia mangostana L.) leaf extract: Comparative preliminary in vitro antibacterial study
- Simultaneous determination of lesinurad and febuxostat in commercial fixed-dose combinations using a greener normal-phase HPTLC method
- A greener RP-HPLC method for quaternary estimation of caffeine, paracetamol, levocetirizine, and phenylephrine acquiring AQbD with stability studies
- Optimization of biomass durian peel as a heterogeneous catalyst in biodiesel production using microwave irradiation
- Thermal treatment impact on the evolution of active phases in layered double hydroxide-based ZnCr photocatalysts: Photodegradation and antibacterial performance
- Preparation of silymarin-loaded zein polysaccharide core–shell nanostructures and evaluation of their biological potentials
- Preparation and characterization of composite-modified PA6 fiber for spectral heating and heat storage applications
- Preparation and electrocatalytic oxygen evolution of bimetallic phosphates (NiFe)2P/NF
- Rod-shaped Mo(vi) trichalcogenide–Mo(vi) oxide decorated on poly(1-H pyrrole) as a promising nanocomposite photoelectrode for green hydrogen generation from sewage water with high efficiency
- Green synthesis and studies on citrus medica leaf extract-mediated Au–ZnO nanocomposites: A sustainable approach for efficient photocatalytic degradation of rhodamine B dye in aqueous media
- Cellulosic materials for the removal of ciprofloxacin from aqueous environments
- The analytical assessment of metal contamination in industrial soils of Saudi Arabia using the inductively coupled plasma technology
- The effect of modified oily sludge on the slurry ability and combustion performance of coal water slurry
- Eggshell waste transformation to calcium chloride anhydride as food-grade additive and eggshell membranes as enzyme immobilization carrier
- Synthesis of EPAN and applications in the encapsulation of potassium humate
- Biosynthesis and characterization of silver nanoparticles from Cedrela toona leaf extracts: An exploration into their antibacterial, anticancer, and antioxidant potential
- Enhancing mechanical and rheological properties of HDPE films through annealing for eco-friendly agricultural applications
- Immobilisation of catalase purified from mushroom (Hydnum repandum) onto glutaraldehyde-activated chitosan and characterisation: Its application for the removal of hydrogen peroxide from artificial wastewater
- Sodium titanium oxide/zinc oxide (STO/ZnO) photocomposites for efficient dye degradation applications
- Effect of ex situ, eco-friendly ZnONPs incorporating green synthesised Moringa oleifera leaf extract in enhancing biochemical and molecular aspects of Vicia faba L. under salt stress
- Biosynthesis and characterization of selenium and silver nanoparticles using Trichoderma viride filtrate and their impact on Culex pipiens
- Photocatalytic degradation of organic dyes and biological potentials of biogenic zinc oxide nanoparticles synthesized using the polar extract of Cyperus scariosus R.Br. (Cyperaceae)
- Assessment of antiproliferative activity of green-synthesized nickel oxide nanoparticles against glioblastoma cells using Terminalia chebula
- Chlorine-free synthesis of phosphinic derivatives by change in the P-function
- Anticancer, antioxidant, and antimicrobial activities of nanoemulsions based on water-in-olive oil and loaded on biogenic silver nanoparticles
- Study and mechanism of formation of phosphorus production waste in Kazakhstan
- Synthesis and stabilization of anatase form of biomimetic TiO2 nanoparticles for enhancing anti-tumor potential
- Microwave-supported one-pot reaction for the synthesis of 5-alkyl/arylidene-2-(morpholin/thiomorpholin-4-yl)-1,3-thiazol-4(5H)-one derivatives over MgO solid base
- Screening the phytochemicals in Perilla leaves and phytosynthesis of bioactive silver nanoparticles for potential antioxidant and wound-healing application
- Graphene oxide/chitosan/manganese/folic acid-brucine functionalized nanocomposites show anticancer activity against liver cancer cells
- Nature of serpentinite interactions with low-concentration sulfuric acid solutions
- Multi-objective statistical optimisation utilising response surface methodology to predict engine performance using biofuels from waste plastic oil in CRDi engines
- Microwave-assisted extraction of acetosolv lignin from sugarcane bagasse and electrospinning of lignin/PEO nanofibres for carbon fibre production
- Biosynthesis, characterization, and investigation of cytotoxic activities of selenium nanoparticles utilizing Limosilactobacillus fermentum
- Highly photocatalytic materials based on the decoration of poly(O-chloroaniline) with molybdenum trichalcogenide oxide for green hydrogen generation from Red Sea water
- Highly efficient oil–water separation using superhydrophobic cellulose aerogels derived from corn straw
- Beta-cyclodextrin–Phyllanthus emblica emulsion for zinc oxide nanoparticles: Characteristics and photocatalysis
- Assessment of antimicrobial activity and methyl orange dye removal by Klebsiella pneumoniae-mediated silver nanoparticles
- Influential eradication of resistant Salmonella Typhimurium using bioactive nanocomposites from chitosan and radish seed-synthesized nanoselenium
- Antimicrobial activities and neuroprotective potential for Alzheimer’s disease of pure, Mn, Co, and Al-doped ZnO ultra-small nanoparticles
- Green synthesis of silver nanoparticles from Bauhinia variegata and their biological applications
- Synthesis and optimization of long-chain fatty acids via the oxidation of long-chain fatty alcohols
- Eminent Red Sea water hydrogen generation via a Pb(ii)-iodide/poly(1H-pyrrole) nanocomposite photocathode
- Green synthesis and effective genistein production by fungal β-glucosidase immobilized on Al2O3 nanocrystals synthesized in Cajanus cajan L. (Millsp.) leaf extracts
- Green stability-indicating RP-HPTLC technique for determining croconazole hydrochloride
- Green synthesis of La2O3–LaPO4 nanocomposites using Charybdis natator for DNA binding, cytotoxic, catalytic, and luminescence applications
- Eco-friendly drugs induce cellular changes in colistin-resistant bacteria
- Tangerine fruit peel extract mediated biogenic synthesized silver nanoparticles and their potential antimicrobial, antioxidant, and cytotoxic assessments
- Green synthesis on performance characteristics of a direct injection diesel engine using sandbox seed oil
- A highly sensitive β-AKBA-Ag-based fluorescent “turn off” chemosensor for rapid detection of abamectin in tomatoes
- Green synthesis and physical characterization of zinc oxide nanoparticles (ZnO NPs) derived from the methanol extract of Euphorbia dracunculoides Lam. (Euphorbiaceae) with enhanced biosafe applications
- Detection of morphine and data processing using surface plasmon resonance imaging sensor
- Effects of nanoparticles on the anaerobic digestion properties of sulfamethoxazole-containing chicken manure and analysis of bio-enzymes
- Bromic acid-thiourea synergistic leaching of sulfide gold ore
- Green chemistry approach to synthesize titanium dioxide nanoparticles using Fagonia Cretica extract, novel strategy for developing antimicrobial and antidiabetic therapies
- Green synthesis and effective utilization of biogenic Al2O3-nanocoupled fungal lipase in the resolution of active homochiral 2-octanol and its immobilization via aluminium oxide nanoparticles
- Eco-friendly RP-HPLC approach for simultaneously estimating the promising combination of pentoxifylline and simvastatin in therapeutic potential for breast cancer: Appraisal of greenness, whiteness, and Box–Behnken design
- Use of a humidity adsorbent derived from cockleshell waste in Thai fried fish crackers (Keropok)
- One-pot green synthesis, biological evaluation, and in silico study of pyrazole derivatives obtained from chalcones
- Bio-sorption of methylene blue and production of biofuel by brown alga Cystoseira sp. collected from Neom region, Kingdom of Saudi Arabia
- Synthesis of motexafin gadolinium: A promising radiosensitizer and imaging agent for cancer therapy
- The impact of varying sizes of silver nanoparticles on the induction of cellular damage in Klebsiella pneumoniae involving diverse mechanisms
- Microwave-assisted green synthesis, characterization, and in vitro antibacterial activity of NiO nanoparticles obtained from lemon peel extract
- Rhus microphylla-mediated biosynthesis of copper oxide nanoparticles for enhanced antibacterial and antibiofilm efficacy
- Harnessing trichalcogenide–molybdenum(vi) sulfide and molybdenum(vi) oxide within poly(1-amino-2-mercaptobenzene) frameworks as a photocathode for sustainable green hydrogen production from seawater without sacrificial agents
- Magnetically recyclable Fe3O4@SiO2 supported phosphonium ionic liquids for efficient and sustainable transformation of CO2 into oxazolidinones
- A comparative study of Fagonia arabica fabricated silver sulfide nanoparticles (Ag2S) and silver nanoparticles (AgNPs) with distinct antimicrobial, anticancer, and antioxidant properties
- Visible light photocatalytic degradation and biological activities of Aegle marmelos-mediated cerium oxide nanoparticles
- Physical intrinsic characteristics of spheroidal particles in coal gasification fine slag
- Exploring the effect of tea dust magnetic biochar on agricultural crops grown in polycyclic aromatic hydrocarbon contaminated soil
- Crosslinked chitosan-modified ultrafiltration membranes for efficient surface water treatment and enhanced anti-fouling performances
- Study on adsorption characteristics of biochars and their modified biochars for removal of organic dyes from aqueous solution
- Zein polymer nanocarrier for Ocimum basilicum var. purpurascens extract: Potential biomedical use
- Green synthesis, characterization, and in vitro and in vivo biological screening of iron oxide nanoparticles (Fe3O4) generated with hydroalcoholic extract of aerial parts of Euphorbia milii
- Novel microwave-based green approach for the synthesis of dual-loaded cyclodextrin nanosponges: Characterization, pharmacodynamics, and pharmacokinetics evaluation
- Bi2O3–BiOCl/poly-m-methyl aniline nanocomposite thin film for broad-spectrum light-sensing
- Green synthesis and characterization of CuO/ZnO nanocomposite using Musa acuminata leaf extract for cytotoxic studies on colorectal cancer cells (HCC2998)
- Review Articles
- Materials-based drug delivery approaches: Recent advances and future perspectives
- A review of thermal treatment for bamboo and its composites
- An overview of the role of nanoherbicides in tackling challenges of weed management in wheat: A novel approach
- An updated review on carbon nanomaterials: Types, synthesis, functionalization and applications, degradation and toxicity
- Special Issue: Emerging green nanomaterials for sustainable waste management and biomedical applications
- Green synthesis of silver nanoparticles using mature-pseudostem extracts of Alpinia nigra and their bioactivities
- Special Issue: New insights into nanopythotechnology: current trends and future prospects
- Green synthesis of FeO nanoparticles from coffee and its application for antibacterial, antifungal, and anti-oxidation activity
- Dye degradation activity of biogenically synthesized Cu/Fe/Ag trimetallic nanoparticles
- Special Issue: Composites and green composites
- Recent trends and advancements in the utilization of green composites and polymeric nanocarriers for enhancing food quality and sustainable processing
- Retraction
- Retraction of “Biosynthesis and characterization of silver nanoparticles from Cedrela toona leaf extracts: An exploration into their antibacterial, anticancer, and antioxidant potential”
- Retraction of “Photocatalytic degradation of organic dyes and biological potentials of biogenic zinc oxide nanoparticles synthesized using the polar extract of Cyperus scariosus R.Br. (Cyperaceae)”
- Retraction to “Green synthesis on performance characteristics of a direct injection diesel engine using sandbox seed oil”
Articles in the same Issue
- Research Articles
- Green polymer electrolyte and activated charcoal-based supercapacitor for energy harvesting application: Electrochemical characteristics
- Research on the adsorption of Co2+ ions using halloysite clay and the ability to recover them by electrodeposition method
- Simultaneous estimation of ibuprofen, caffeine, and paracetamol in commercial products using a green reverse-phase HPTLC method
- Isolation, screening and optimization of alkaliphilic cellulolytic fungi for production of cellulase
- Functionalized gold nanoparticles coated with bacterial alginate and their antibacterial and anticancer activities
- Comparative analysis of bio-based amino acid surfactants obtained via Diels–Alder reaction of cyclic anhydrides
- Biosynthesis of silver nanoparticles on yellow phosphorus slag and its application in organic coatings
- Exploring antioxidant potential and phenolic compound extraction from Vitis vinifera L. using ultrasound-assisted extraction
- Manganese and copper-coated nickel oxide nanoparticles synthesized from Carica papaya leaf extract induce antimicrobial activity and breast cancer cell death by triggering mitochondrial caspases and p53
- Insight into heating method and Mozafari method as green processing techniques for the synthesis of micro- and nano-drug carriers
- Silicotungstic acid supported on Bi-based MOF-derived metal oxide for photodegradation of organic dyes
- Synthesis and characterization of capsaicin nanoparticles: An attempt to enhance its bioavailability and pharmacological actions
- Synthesis of Lawsonia inermis-encased silver–copper bimetallic nanoparticles with antioxidant, antibacterial, and cytotoxic activity
- Facile, polyherbal drug-mediated green synthesis of CuO nanoparticles and their potent biological applications
- Zinc oxide-manganese oxide/carboxymethyl cellulose-folic acid-sesamol hybrid nanomaterials: A molecularly targeted strategy for advanced triple-negative breast cancer therapy
- Exploring the antimicrobial potential of biogenically synthesized graphene oxide nanoparticles against targeted bacterial and fungal pathogens
- Biofabrication of silver nanoparticles using Uncaria tomentosa L.: Insight into characterization, antibacterial activities combined with antibiotics, and effect on Triticum aestivum germination
- Membrane distillation of synthetic urine for use in space structural habitat systems
- Investigation on mechanical properties of the green synthesis bamboo fiber/eggshell/coconut shell powder-based hybrid biocomposites under NaOH conditions
- Green synthesis of magnesium oxide nanoparticles using endophytic fungal strain to improve the growth, metabolic activities, yield traits, and phenolic compounds content of Nigella sativa L.
- Estimation of greenhouse gas emissions from rice and annual upland crops in Red River Delta of Vietnam using the denitrification–decomposition model
- Synthesis of humic acid with the obtaining of potassium humate based on coal waste from the Lenger deposit, Kazakhstan
- Ascorbic acid-mediated selenium nanoparticles as potential antihyperuricemic, antioxidant, anticoagulant, and thrombolytic agents
- Green synthesis of silver nanoparticles using Illicium verum extract: Optimization and characterization for biomedical applications
- Antibacterial and dynamical behaviour of silicon nanoparticles influenced sustainable waste flax fibre-reinforced epoxy composite for biomedical application
- Optimising coagulation/flocculation using response surface methodology and application of floc in biofertilisation
- Green synthesis and multifaceted characterization of iron oxide nanoparticles derived from Senna bicapsularis for enhanced in vitro and in vivo biological investigation
- Potent antibacterial nanocomposites from okra mucilage/chitosan/silver nanoparticles for multidrug-resistant Salmonella Typhimurium eradication
- Trachyspermum copticum aqueous seed extract-derived silver nanoparticles: Exploration of their structural characterization and comparative antibacterial performance against gram-positive and gram-negative bacteria
- Microwave-assisted ultrafine silver nanoparticle synthesis using Mitragyna speciosa for antimalarial applications
- Green synthesis and characterisation of spherical structure Ag/Fe2O3/TiO2 nanocomposite using acacia in the presence of neem and tulsi oils
- Green quantitative methods for linagliptin and empagliflozin in dosage forms
- Enhancement efficacy of omeprazole by conjugation with silver nanoparticles as a urease inhibitor
- Residual, sequential extraction, and ecological risk assessment of some metals in ash from municipal solid waste incineration, Vietnam
- Green synthesis of ZnO nanoparticles using the mangosteen (Garcinia mangostana L.) leaf extract: Comparative preliminary in vitro antibacterial study
- Simultaneous determination of lesinurad and febuxostat in commercial fixed-dose combinations using a greener normal-phase HPTLC method
- A greener RP-HPLC method for quaternary estimation of caffeine, paracetamol, levocetirizine, and phenylephrine acquiring AQbD with stability studies
- Optimization of biomass durian peel as a heterogeneous catalyst in biodiesel production using microwave irradiation
- Thermal treatment impact on the evolution of active phases in layered double hydroxide-based ZnCr photocatalysts: Photodegradation and antibacterial performance
- Preparation of silymarin-loaded zein polysaccharide core–shell nanostructures and evaluation of their biological potentials
- Preparation and characterization of composite-modified PA6 fiber for spectral heating and heat storage applications
- Preparation and electrocatalytic oxygen evolution of bimetallic phosphates (NiFe)2P/NF
- Rod-shaped Mo(vi) trichalcogenide–Mo(vi) oxide decorated on poly(1-H pyrrole) as a promising nanocomposite photoelectrode for green hydrogen generation from sewage water with high efficiency
- Green synthesis and studies on citrus medica leaf extract-mediated Au–ZnO nanocomposites: A sustainable approach for efficient photocatalytic degradation of rhodamine B dye in aqueous media
- Cellulosic materials for the removal of ciprofloxacin from aqueous environments
- The analytical assessment of metal contamination in industrial soils of Saudi Arabia using the inductively coupled plasma technology
- The effect of modified oily sludge on the slurry ability and combustion performance of coal water slurry
- Eggshell waste transformation to calcium chloride anhydride as food-grade additive and eggshell membranes as enzyme immobilization carrier
- Synthesis of EPAN and applications in the encapsulation of potassium humate
- Biosynthesis and characterization of silver nanoparticles from Cedrela toona leaf extracts: An exploration into their antibacterial, anticancer, and antioxidant potential
- Enhancing mechanical and rheological properties of HDPE films through annealing for eco-friendly agricultural applications
- Immobilisation of catalase purified from mushroom (Hydnum repandum) onto glutaraldehyde-activated chitosan and characterisation: Its application for the removal of hydrogen peroxide from artificial wastewater
- Sodium titanium oxide/zinc oxide (STO/ZnO) photocomposites for efficient dye degradation applications
- Effect of ex situ, eco-friendly ZnONPs incorporating green synthesised Moringa oleifera leaf extract in enhancing biochemical and molecular aspects of Vicia faba L. under salt stress
- Biosynthesis and characterization of selenium and silver nanoparticles using Trichoderma viride filtrate and their impact on Culex pipiens
- Photocatalytic degradation of organic dyes and biological potentials of biogenic zinc oxide nanoparticles synthesized using the polar extract of Cyperus scariosus R.Br. (Cyperaceae)
- Assessment of antiproliferative activity of green-synthesized nickel oxide nanoparticles against glioblastoma cells using Terminalia chebula
- Chlorine-free synthesis of phosphinic derivatives by change in the P-function
- Anticancer, antioxidant, and antimicrobial activities of nanoemulsions based on water-in-olive oil and loaded on biogenic silver nanoparticles
- Study and mechanism of formation of phosphorus production waste in Kazakhstan
- Synthesis and stabilization of anatase form of biomimetic TiO2 nanoparticles for enhancing anti-tumor potential
- Microwave-supported one-pot reaction for the synthesis of 5-alkyl/arylidene-2-(morpholin/thiomorpholin-4-yl)-1,3-thiazol-4(5H)-one derivatives over MgO solid base
- Screening the phytochemicals in Perilla leaves and phytosynthesis of bioactive silver nanoparticles for potential antioxidant and wound-healing application
- Graphene oxide/chitosan/manganese/folic acid-brucine functionalized nanocomposites show anticancer activity against liver cancer cells
- Nature of serpentinite interactions with low-concentration sulfuric acid solutions
- Multi-objective statistical optimisation utilising response surface methodology to predict engine performance using biofuels from waste plastic oil in CRDi engines
- Microwave-assisted extraction of acetosolv lignin from sugarcane bagasse and electrospinning of lignin/PEO nanofibres for carbon fibre production
- Biosynthesis, characterization, and investigation of cytotoxic activities of selenium nanoparticles utilizing Limosilactobacillus fermentum
- Highly photocatalytic materials based on the decoration of poly(O-chloroaniline) with molybdenum trichalcogenide oxide for green hydrogen generation from Red Sea water
- Highly efficient oil–water separation using superhydrophobic cellulose aerogels derived from corn straw
- Beta-cyclodextrin–Phyllanthus emblica emulsion for zinc oxide nanoparticles: Characteristics and photocatalysis
- Assessment of antimicrobial activity and methyl orange dye removal by Klebsiella pneumoniae-mediated silver nanoparticles
- Influential eradication of resistant Salmonella Typhimurium using bioactive nanocomposites from chitosan and radish seed-synthesized nanoselenium
- Antimicrobial activities and neuroprotective potential for Alzheimer’s disease of pure, Mn, Co, and Al-doped ZnO ultra-small nanoparticles
- Green synthesis of silver nanoparticles from Bauhinia variegata and their biological applications
- Synthesis and optimization of long-chain fatty acids via the oxidation of long-chain fatty alcohols
- Eminent Red Sea water hydrogen generation via a Pb(ii)-iodide/poly(1H-pyrrole) nanocomposite photocathode
- Green synthesis and effective genistein production by fungal β-glucosidase immobilized on Al2O3 nanocrystals synthesized in Cajanus cajan L. (Millsp.) leaf extracts
- Green stability-indicating RP-HPTLC technique for determining croconazole hydrochloride
- Green synthesis of La2O3–LaPO4 nanocomposites using Charybdis natator for DNA binding, cytotoxic, catalytic, and luminescence applications
- Eco-friendly drugs induce cellular changes in colistin-resistant bacteria
- Tangerine fruit peel extract mediated biogenic synthesized silver nanoparticles and their potential antimicrobial, antioxidant, and cytotoxic assessments
- Green synthesis on performance characteristics of a direct injection diesel engine using sandbox seed oil
- A highly sensitive β-AKBA-Ag-based fluorescent “turn off” chemosensor for rapid detection of abamectin in tomatoes
- Green synthesis and physical characterization of zinc oxide nanoparticles (ZnO NPs) derived from the methanol extract of Euphorbia dracunculoides Lam. (Euphorbiaceae) with enhanced biosafe applications
- Detection of morphine and data processing using surface plasmon resonance imaging sensor
- Effects of nanoparticles on the anaerobic digestion properties of sulfamethoxazole-containing chicken manure and analysis of bio-enzymes
- Bromic acid-thiourea synergistic leaching of sulfide gold ore
- Green chemistry approach to synthesize titanium dioxide nanoparticles using Fagonia Cretica extract, novel strategy for developing antimicrobial and antidiabetic therapies
- Green synthesis and effective utilization of biogenic Al2O3-nanocoupled fungal lipase in the resolution of active homochiral 2-octanol and its immobilization via aluminium oxide nanoparticles
- Eco-friendly RP-HPLC approach for simultaneously estimating the promising combination of pentoxifylline and simvastatin in therapeutic potential for breast cancer: Appraisal of greenness, whiteness, and Box–Behnken design
- Use of a humidity adsorbent derived from cockleshell waste in Thai fried fish crackers (Keropok)
- One-pot green synthesis, biological evaluation, and in silico study of pyrazole derivatives obtained from chalcones
- Bio-sorption of methylene blue and production of biofuel by brown alga Cystoseira sp. collected from Neom region, Kingdom of Saudi Arabia
- Synthesis of motexafin gadolinium: A promising radiosensitizer and imaging agent for cancer therapy
- The impact of varying sizes of silver nanoparticles on the induction of cellular damage in Klebsiella pneumoniae involving diverse mechanisms
- Microwave-assisted green synthesis, characterization, and in vitro antibacterial activity of NiO nanoparticles obtained from lemon peel extract
- Rhus microphylla-mediated biosynthesis of copper oxide nanoparticles for enhanced antibacterial and antibiofilm efficacy
- Harnessing trichalcogenide–molybdenum(vi) sulfide and molybdenum(vi) oxide within poly(1-amino-2-mercaptobenzene) frameworks as a photocathode for sustainable green hydrogen production from seawater without sacrificial agents
- Magnetically recyclable Fe3O4@SiO2 supported phosphonium ionic liquids for efficient and sustainable transformation of CO2 into oxazolidinones
- A comparative study of Fagonia arabica fabricated silver sulfide nanoparticles (Ag2S) and silver nanoparticles (AgNPs) with distinct antimicrobial, anticancer, and antioxidant properties
- Visible light photocatalytic degradation and biological activities of Aegle marmelos-mediated cerium oxide nanoparticles
- Physical intrinsic characteristics of spheroidal particles in coal gasification fine slag
- Exploring the effect of tea dust magnetic biochar on agricultural crops grown in polycyclic aromatic hydrocarbon contaminated soil
- Crosslinked chitosan-modified ultrafiltration membranes for efficient surface water treatment and enhanced anti-fouling performances
- Study on adsorption characteristics of biochars and their modified biochars for removal of organic dyes from aqueous solution
- Zein polymer nanocarrier for Ocimum basilicum var. purpurascens extract: Potential biomedical use
- Green synthesis, characterization, and in vitro and in vivo biological screening of iron oxide nanoparticles (Fe3O4) generated with hydroalcoholic extract of aerial parts of Euphorbia milii
- Novel microwave-based green approach for the synthesis of dual-loaded cyclodextrin nanosponges: Characterization, pharmacodynamics, and pharmacokinetics evaluation
- Bi2O3–BiOCl/poly-m-methyl aniline nanocomposite thin film for broad-spectrum light-sensing
- Green synthesis and characterization of CuO/ZnO nanocomposite using Musa acuminata leaf extract for cytotoxic studies on colorectal cancer cells (HCC2998)
- Review Articles
- Materials-based drug delivery approaches: Recent advances and future perspectives
- A review of thermal treatment for bamboo and its composites
- An overview of the role of nanoherbicides in tackling challenges of weed management in wheat: A novel approach
- An updated review on carbon nanomaterials: Types, synthesis, functionalization and applications, degradation and toxicity
- Special Issue: Emerging green nanomaterials for sustainable waste management and biomedical applications
- Green synthesis of silver nanoparticles using mature-pseudostem extracts of Alpinia nigra and their bioactivities
- Special Issue: New insights into nanopythotechnology: current trends and future prospects
- Green synthesis of FeO nanoparticles from coffee and its application for antibacterial, antifungal, and anti-oxidation activity
- Dye degradation activity of biogenically synthesized Cu/Fe/Ag trimetallic nanoparticles
- Special Issue: Composites and green composites
- Recent trends and advancements in the utilization of green composites and polymeric nanocarriers for enhancing food quality and sustainable processing
- Retraction
- Retraction of “Biosynthesis and characterization of silver nanoparticles from Cedrela toona leaf extracts: An exploration into their antibacterial, anticancer, and antioxidant potential”
- Retraction of “Photocatalytic degradation of organic dyes and biological potentials of biogenic zinc oxide nanoparticles synthesized using the polar extract of Cyperus scariosus R.Br. (Cyperaceae)”
- Retraction to “Green synthesis on performance characteristics of a direct injection diesel engine using sandbox seed oil”

